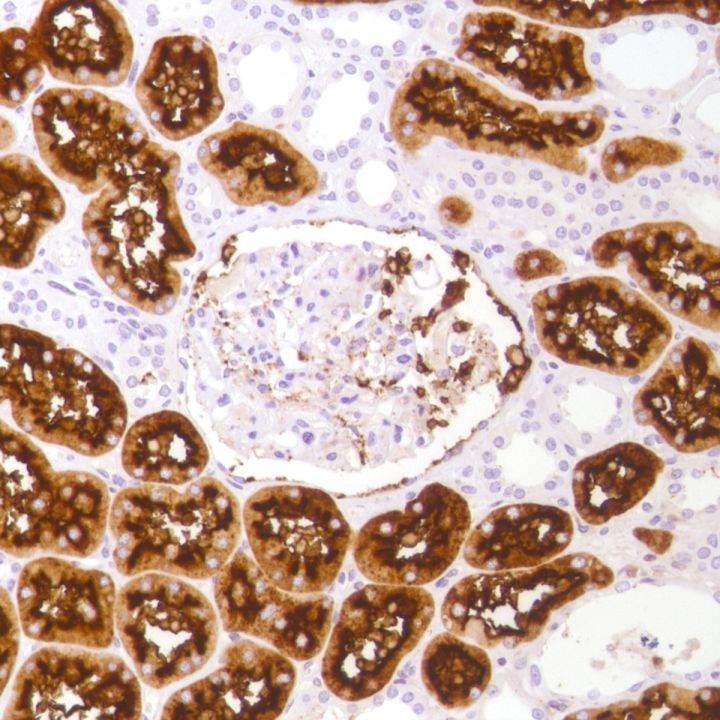

.jpg)
CD13 (SP182)
CD13, also known as aminopeptidase N, participates in the final digestion of peptides from stomach, pancreas, and other organs. It expresses by perse cell types including small intestinal and tubular epithelial cells, macrophages, granulocytes and synaptic membranes. It may be involved in the cleavage of antigen peptides, degradation of neurotransmitters, and angiogenesis. It is one of the useful markers for acute myeloid leukemia or lymphoma.
....Related Files
1205_M482(CD13).pdf (54.9Kb)